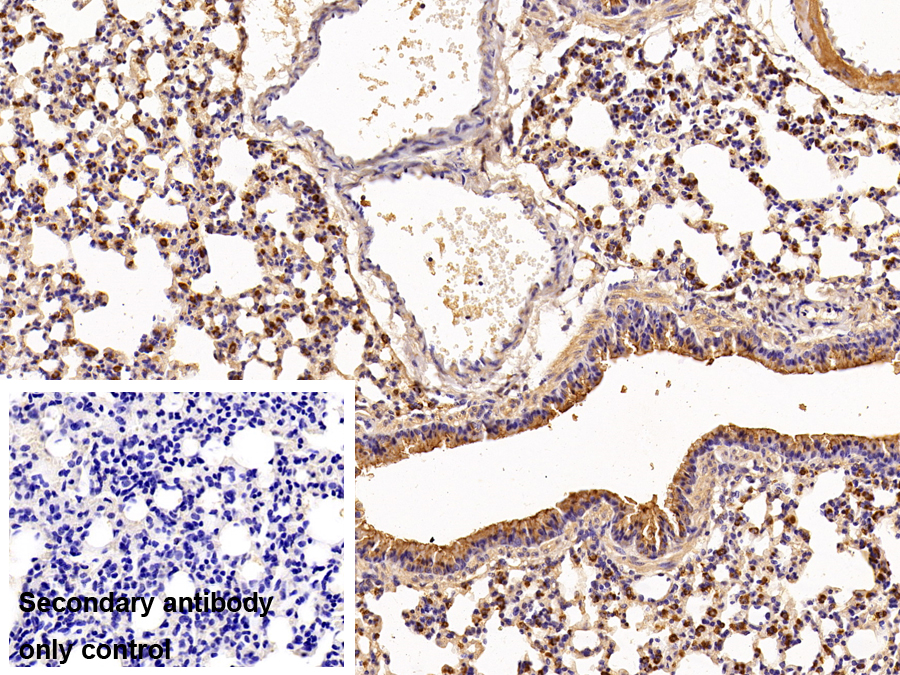

Polyclonal Antibody to Surfactant Protein B (SP-B) 

SFTPB; PSPB; SFTB3; SFTP3; SPB; Surfactant Associated Protein B; Pulmonary Surfactant Protein B; 18 kDa pulmonary-surfactant protein; 6 kDa protein
Overview
Properties
- Product No.PAB622Mu01
- Organism SpeciesMus musculus (Mouse) Same name, Different species.
- ApplicationsWB; IHC
If the antibody is used in flow cytometry, please check FCM antibodies.
Research use only - DownloadInstruction Manual
- CategoryTumor immunityInfection immunityPulmonology
- SourcePolyclonal antibody preparation, Host Rabbit
- Ig Type IgG, Potency n/a
- PurificationAntigen-specific affinity chromatography followed by Protein A affinity chromatography
- LabelNone
- Immunogen RPB622Mu01-Recombinant Surfactant Protein B (SP-B)
- Buffer FormulationPBS, pH7.4, containing 0.02% NaN3, 50% glycerol.
- TraitsLiquid, Concentration 0.5mg/mL
Sign into your account
Share a new citation as an author
Upload your experimental result
Review

Contact us
Please fill in the blank.
Specifity
The antibody is a rabbit polyclonal antibody raised against SP-B. It has been selected for its ability to recognize SP-B in immunohistochemical staining and western blotting.
Usage
Western blotting: 0.01-2µg/mL;
Immunohistochemistry: 5-20µg/mL;
Optimal working dilutions must be determined by end user.
Storage
Store at 4°C for frequent use. Stored at -20°C in a manual defrost freezer for two year without detectable loss of activity. Avoid repeated freeze-thaw cycles.
Stability
The thermal stability is described by the loss rate. The loss rate was determined by accelerated thermal degradation test, that is, incubate the protein at 37°C for 48h, and no obvious degradation and precipitation were observed. The loss rate is less than 5% within the expiration date under appropriate storage condition.
Giveaways
Increment services
-
 Antibody Labeling Customized Service
Antibody Labeling Customized Service
-
 Protein A/G Purification Column
Protein A/G Purification Column
-
 Staining Solution for Cells and Tissue
Staining Solution for Cells and Tissue
-
 Positive Control for Antibody
Positive Control for Antibody
-
 Tissue/Sections Customized Service
Tissue/Sections Customized Service
-
 Phosphorylated Antibody Customized Service
Phosphorylated Antibody Customized Service
-
 Western Blot (WB) Experiment Service
Western Blot (WB) Experiment Service
-
 Immunohistochemistry (IHC) Experiment Service
Immunohistochemistry (IHC) Experiment Service
-
 Immunocytochemistry (ICC) Experiment Service
Immunocytochemistry (ICC) Experiment Service
-
 Flow Cytometry (FCM) Experiment Service
Flow Cytometry (FCM) Experiment Service
-
 Immunoprecipitation (IP) Experiment Service
Immunoprecipitation (IP) Experiment Service
-
 Immunofluorescence (IF) Experiment Service
Immunofluorescence (IF) Experiment Service
-
 Buffer
Buffer
-
 DAB Chromogen Kit
DAB Chromogen Kit
-
 SABC Kit
SABC Kit
-
 Long-arm Biotin Labeling Kit
Long-arm Biotin Labeling Kit
-
 Real Time PCR Experimental Service
Real Time PCR Experimental Service
Citations
- Kinetics of plasma SPB and RAGE during mechanical ventilation in patients undergoing major vascular surgeryPubMed: 21736957
- Detection of surfactant proteins A, B, C, and D in human nasal mucosa and their regulation in chronic rhinosinusitis with polypsPubMed: 23406594
- Surfactant protein B and RAGE increases in the plasma during cardiopulmonary bypass: a pilot studyPubMed: 20650982
- Staphylococcus aureus and Pseudomonas aeruginosa Express and Secrete Human Surfactant ProteinsPubMed: PMC3551896
- The Detection of Surfactant Proteins A, B, C and D in the Human Brain and Their Regulation in Cerebral Infarction, Autoimmune Conditions and Infections of the CNSPubMed: PMC3787032
- Lung Cancer Signatures in Plasma Based on Proteome Profiling of Mouse Tumor ModelsPubMed: PMC3406925
- Acute high-altitude exposure reduces lung diffusion: Data from the HIGHCARE Alps projectPubmed: 23619193
- Surfactant-Derived Proteins as Markers of Alveolar Membrane Damage in Heart FailurePubmed:25514679
- Nachweis und Charakterisierung des Oberfl?chenproteins PLUNC (Palate, Lung and Nasal Clone Protein) an der Augenoberfl?che und Bedeutung für das Trockene AugeOpus4:Source
- Plasma immature form of surfactant protein type B correlates with prognosis in patients with chronic heart failure. A pilot single-center prospective studyPubMed: 26310985
- Serum Levels of Surfactant Proteins in Patients with Combined Pulmonary Fibrosis and Emphysema (CPFE)Pubmed:27337142
- The Cerebral Surfactant System and Its Alteration in HydrocephalicConditions.pubmed:27656877
- Correlations of Ventricular Enlargement with Rheologically Active SurfactantProteins in Cerebrospinal Fluid.pubmed:28101052
- Correlations of Ventricular Enlargement with Rheologically Active Surfactant Proteins in Cerebrospinal FluidPMC5209370
- Diving and pulmonary physiology: surfactant binding protein, lung fluid and cardiopulmonary test changes in professional diverspubmed:28467885
- Surfactant Protein B Suppresses Lung Cancer Progression by Inhibiting Secretory Phospholipase A2 Activity and Arachidonic Acid Productionpubmed:28743125
- Chronic lung injury and impaired pulmonary function in a mouse model of acid ceramidase deficiency.pubmed:29167126
- Effects and molecular mechanisms of intrauterine infection/inflammation on lung developmentPubmed:29747649
- Surfactant proteins changes after acute hemodynamic improvement in patients with advanced chronic heart failure treated with LevosimendanPubmed:29548887
- Serum Surfactant Protein Levels in Patients Admitted to the Hospital with Acute COPD ExacerbationPubmed:29445934
- Generation of an alveolar epithelial type II cell line from induced pluripotent stem cellsPubmed: 30211653
- Culture of human alveolar epithelial type II cells by sproutingPubmed: 30340591